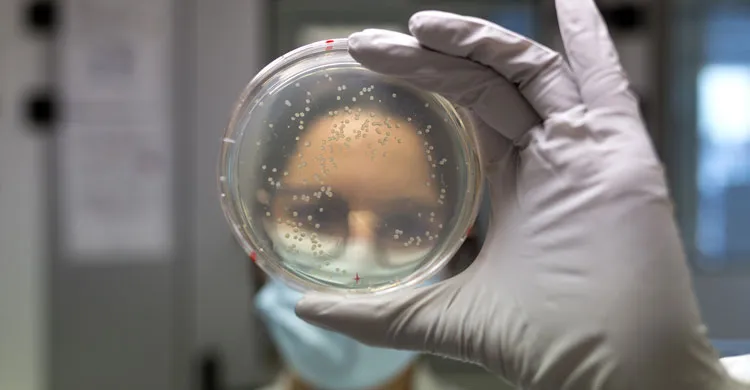
un membre de l'équipe « Immunologie et Thérapie Génique des Maladies du Foie » de Généthon

Genethon launches a pivotal clinical trial in Europe for treatment of Crigler-Najjar syndrome
Genethon, a unique non-profit gene therapy R&D organization founded by the French Muscular Dystrophy Association (AFM-Telethon), has launched a pivotal clinical trial in Europe for treatment of Crigler-Najjar syndrome, a life threatening liver disease, in France, Italy and the Netherlands and will enroll patients aged 10 years and older with the objective of confirming efficacy and safety seen in the previous clinical part.
The European trial, conducted in collaboration with the European consortium CureCN, started in 2017. The initial portion of theclinical trial, which treated six adult patients, confirmed the safety of the product. After a demonstration of transient efficacy in the patients of the first cohort treated with a low dose of the gene therapy, treatment at the higher dose in patients of the second cohort established efficacy over time. The patients had a reduction in bilirubin levels sufficient to discontinue phototherapy for at least one year. The pivotal part of the clinical trial will enroll patients aged 10 years and older with the objective of confirming efficacy and safety seen in the previous clinical part.
"We are very pleased with this new step because if the results of the pivotal part confirm the efficacy of GNT-003, we will be able to move forward towards a registration application and the availability of the treatment for patients,” said Frederic Revah, CEO of Genethon. “This new step demonstrates once again the excellence of the research conducted at Genethon, which is today one of the major players in gene therapy at the international level."
The gene therapy (GNT-0003) was designed by Genethon's Immunology and Gene Therapy of Liver Diseases team, led by Dr. Giuseppe Ronzitti. It would represent a first-of-its kind treatment for this life threatening genetic disease.
Crigler-Najjar syndrome is a rare genetic liver disease characterized by abnormally high levels of bilirubin in the blood (hyperbilirubinemia). High levels of bilirubin can result in significant neurological damage and death if not treated quickly.